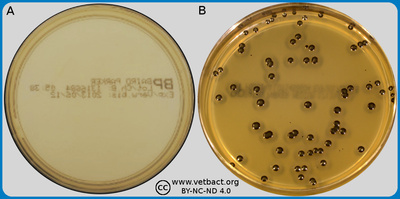
Baird-Parker agar
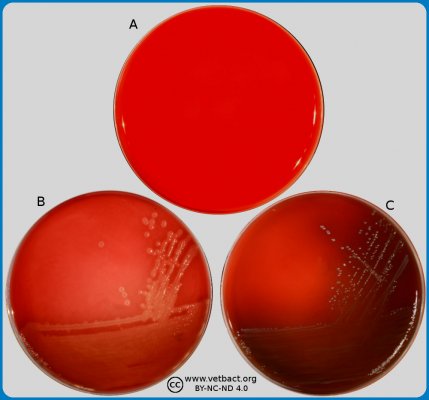
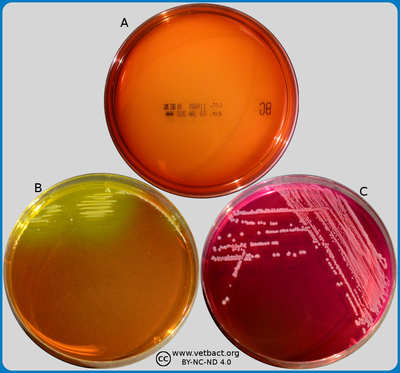
Brilliant Green (BG) Agar
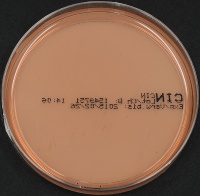
CIN agar plate
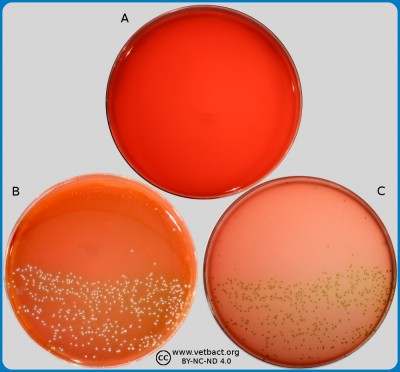
Colistin-Oxolinic Acid-Blood Agar (COBA)
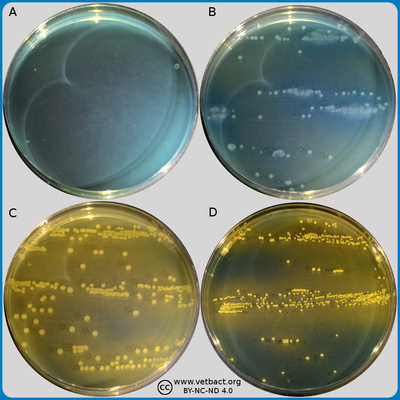
Cysteine Lactose Electrolyte Deficient (CLED) agar
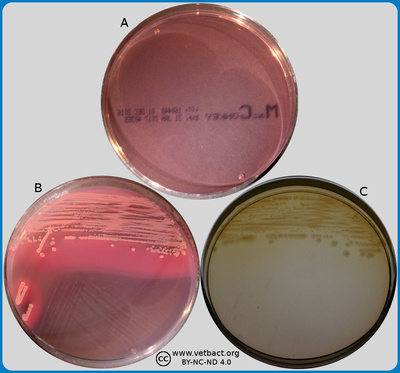
MacConkey agar
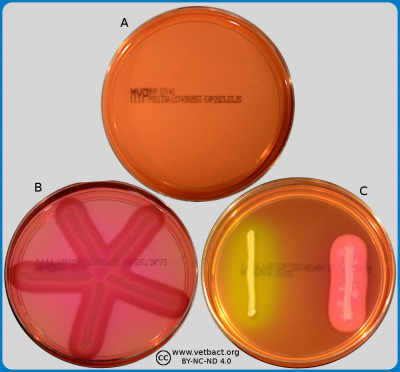
Mannitol egg Yolk Polymyxin agar (MYP agar)
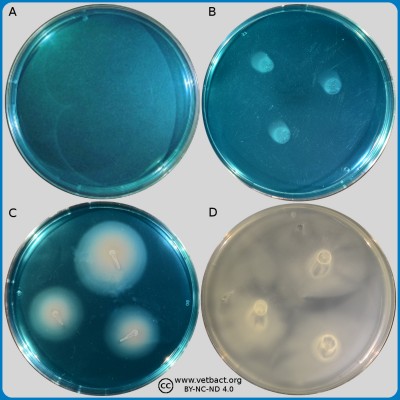
Modified Semisolid Rappaport Vassiliadis (MSRV) agar
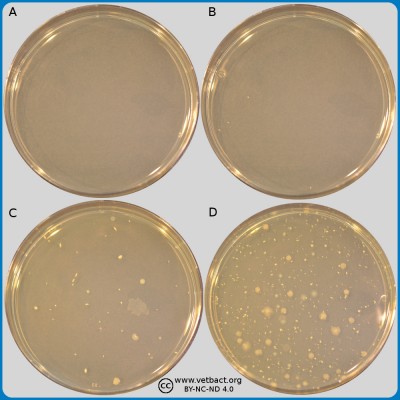
Plate count agar (PCA)
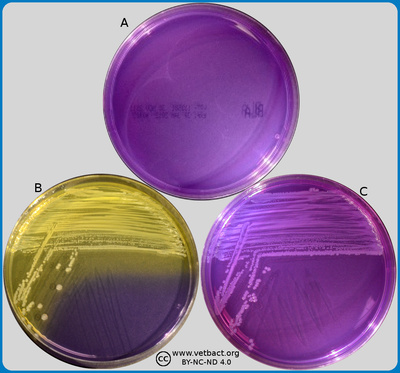
Purple agar
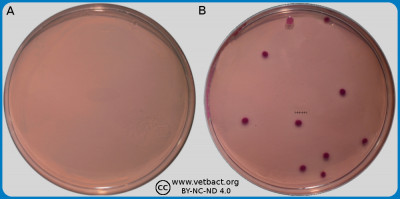
Tryptic soy agar (TSA)
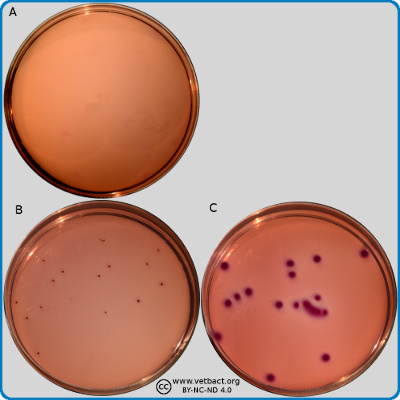
VRBG agar plates

Growth Media
Baird-Parker agar
The figure shows two BP agar plates. Bacteria has not been cultivated on plate A, but on plate B, Staphylococcus aureus subsp. aureus have been cultivated. Note the black colour of the colonies and the double zone around the colonies. - Click on the image to enlarge it.
Image: Ingrid Hansson (SLU), Lise-Lotte Fernström (SLU) & Karl-Erik Johansson (SLU).
Applications
Baird-Parker agar (BP agar) is a selective medium for identification and enumeration of coagulase positive Staphylococcus spp. BP agar is used for detection of Staphylococcus aureus in food, dairy products and cosmetic products. Cultivation is performed after surface streaking and at 37°C.
Baird Parker agar supplemented with acriflavin can be used to differentiate between S. aureus, which is able to grow in the presence of acriflavin, from other DNase positive, hemolytic staphylococci (S. intermedius group).
The medium contains:
- casein peptone (carbon and nitrogen source)
- beef extract (carbon and nitrogen source)
- yeast extract (B vitamins etc.)
- litium chloride [(LiCl) inhibits growth of other bacteria]
- tellurite [(TeO32−) inhibits growth of other bacteria and makes colonies of coagulase positive staphylococci turn black]
- egg yolk (indicator of lecithinase and lipase activity)
- glycine (stimulates growth of Staphylococcus spp.)
- sodium pyruvate (stimulates growth of Staphylococcus spp.)
- agar (gelifying agent)
- H2O
Other comments:
Coagulase positive staphylococci form black colonies, since sodium tellurite is reduced to telluride, which is a black insoluble substance. Lecithinase and lipase activity of coagulase positive staphylococci result in a clear and an opaque zone around the colonies.
Updated: 2018-05-09.
ContentsBlood agar

Applications
Blood agar can be used for isolation and cultivation of fastidious and non-fastidious bacteria. The blood agar plates are incubated at different temperatures and in different atmospheres depending on the actual bacterium.
The medium contains:
- beef extract
- tryptone (contains amino acids)
- NaCl (contributes to the osmotisc balance)
- 5-10% blood (may originate from e.g. cattle, sheep or horses)
- agar (gelifying agent)
Bacteria can also be differentiated, based on their capacity to secrete hemolysins, by cultivation on blood agar. Hemolysins are substances (usually enzymes or porins), which have the capacity to lyse red blood cells. The hemolysis will cause a clearing zone of the blood agar around the colonies. Bacteria can cause different types of hemolysis:
- α-hemolysis, which means an incomplete clearing (green hemolysis).
- β-hemolysis, which means a complete clearing.
- Doubble hemolysis of some staphylococci consisting of an inner α-hemolysis zone and an outer β-hemolysis zone (see also below).
- No hemolysis, which is sometimes referred to as γ-hemolysis, which may seem illogical.
Other comments:
Note that the α-hemolysin of staphylococci causes complete hemolysis, whereas their β-hemolysin causes incomplete hemolysis.
The capacity to produce hemolysins may vary between different strains of a particular bacterial species.
Updated: 2021-05-20.
ContentsBovine blood agar with esculin
The figure shows plates with Bovine Blood agar with Esculin, and no bacteria have been cultivated on plate A. On plate B - Streptococcus agalactaie, has been cultivated. Note that Streptococcus agalactaie is incapable of esculin hydroysis, appear with a strong beta-hemolysis with no darkening of the media, while Streptococcus uberis on playte B is non-haemolytic with darkening of the media. The plate is shown with lighting from above (A) and from below (B). - Click on the image to enlarge it.
Image: Lise-Lotte Fernström (HBIO, SLU) and Ingrid Hansson (HBIO, SLU).
- Click on the image to enlarge it.
Applications
Bovine blood agar with esculin is an agar medium for all common udder pathogenic bacteria. Bovine blood agar with esculin is mainly used in analysis of mastitis samples as it can distinguish ulin to differentiate group D streptococci from Streptococcus agalactae, as S. agalactiae is not capable of esculin-hydrolysis. When esculin is hydrolysed by organisms it forms dextrose and esculin, which react with a compound in the media to produce a darkening around the colonies.
The medium contains:
- beef extract (carbon and nitrogen source)
- tryptose
- esculin
- NaCl (contributes to the osmotic balance)
- 5% bovine blood which contains nutrients and also makes it possible to observe hemolysis
- agar (gelifying agent)
- Water
The final pH of this medium used to be 7.6
Updated: 2024-11-13.
ContentsBrilliance Listeria agar medium
Applications:
Image A shows a plate containing Brilliance™ Listeria Agar before cultivation. Image B shows the same kind of plate on which Listeria monocytogenes has been cultivated at 37°C during 48 hours. Note the unusual colour of the colonies and the turbid zone, which has been formed around these colonies. Click on the image to enlarge (opens in a new window/tab).
Image: Karl-Erik Johansson (BVF, SLU) and Lise-Lotte Fernström (BVF, SLU).
Brilliance™ Listeria Agar from Oxoid was earlier called Oxoid Chromogenic Listeria Agar (OCLA) and it is a medium used for isolation, enumeration and tentative identification of Listeria spp. and Listeria monocytogenes isolated from food samples.
Content of the medium:
- peptone (contains amino acids and peptides)
- yeast extrakt (contains peptides, sugars, minerals and B vitamins)
- NaCl (contributes to the osmotic balance)
- sodium pyruvate
- LiCl
- maltose (carbon source)
- X-glucoside chromogenic mixture
- agar (gelifying agent)
- water
The final pH of the medium should be 7.2.
The medium should then be mixed with two different supplementary solutions. One solution contains antibiotics (nalidixic acid, polymyxin B, ceftazidime and amphotericin). The other solution contains lecithin.
Other comments:
Members of the genus Listeria have a β-glucosidase, which cleaves the X-glucoside to a blue-greenish product. Other bacteria, which have a β-glucosidase are inhibited by the antibiotics, which are present in the medium. L. monocytogenes and pathogenic strains of Listeria ivanovii have a lecithinase, which cleaves lecithin to phosphocholine and a diglyceride. The diglyceride is insoluble and if bacteria, which are cultivated on Brilliance Listeria Agar, have a lecithinase, an opalescent zone will be formed around the colonies because of precipitation of the diglyceride.
Updated: 2018-05-09.
ContentsBrilliant Green (BG) agar
The figure shows three BG agar plates. Bacteria were not cultivated on the plate in image A. On the plate in image B, Escherichia coli has been cultivated. Note that the colour of this plate has changed from yellowish-red to yellow where colonies appear and, therfore, the colonies appear as yellowish. Salmonella sp. has been cultivated on plate C. Note that the colour of this plate has changed from yellowish-red to dark red and that the colonies are pink. E. coli does only grow poorly on BG agar. - Click on the image to enlarge it.
Image: Karl-Erik Johansson (BVF, SLU) and Lise-Lotte Fernström (BVF, SLU).
Applications
Brilliant Green (BG) Agar is used for selective isolation of Salmonella spp.
Content of the medium:
- Yeast extract
- Enzymatic digest of casein
- Enzymatic digest of animal tissue
- NaCl
- Lactose
- Sucrose
- Brilliant green
- Phenol red
- Agar
The enzymatic digests provide sources of nitrogen, amino acids and carbon. The yeast extract supplies vitamins required for growth of bacteria. NaCl maintains the osmotic balance of the medium. Lactose and sucrose are the carbohydrates in the medium. Brilliant green (BG) inhibits gram-positive bacteria and most gram-negative rods other than Salmonella spp. The pH is 6.9. Phenol red is the pH indicator, which turns the yellow upon acidification due to fermentation of lactose and/or sucrose. Agar is the solidifying agent.
Other comments:
- Salmonella colonies appear as red to pink-white, because the agar around the colonies is red. However, the reddish tint can vary depending upon incubation time and strain.
- Lactose- or sucrose fermenters, which are not inhibited by BG, form colonies, which appear to be yellowish and surrounded by a yellow-green zone, because of the pH change.
- Colonies of other non-lactose and non-sucrose fermenters than salmonella, may be similar to salmonella colonies.
- Salmonella enterica subsp. enterica, serovars Typhi and Paratyphi do not grew well on BG agar.
Updated: 2024-03-17.
ContentsBuffered Peptone Water (BPW)

The composition of BPW is peptone, NaCl, Na2HPO4.12H2O, KH2PO4 and water.
Peptone is derived from animal milk or meat digested with a proteolytic enzyme. Peptone is the the sorce of carbon, nitrogen, vitamins and minerals in BPW. Sodium chloride maintains the osmotic balance and the medium is buffered with phosphates (pH = 7.2).
Updated: 2019-09-25.
ContentsCCDA (Charcoal Cefoperozone Deoxycholate agar)
The figure shows two CCDA plates. No sample has has been applied onto the plate in image A. Campylobacter jejuni subsp. jejuni has been cultivated on the plate in image B. The colonies appear as greyish to white and get a metallic sheen if the plate is tilted in the light from a lamp, which can be seen on the CCDA plate on the C. jejuni subsp. jejuni page. - Click on the image to enlarge it.
Image: Karl-Erik Johansson (BVF, SLU) and Lise-Lotte Fernström (BVF, SLU).
Applications:
The medium, which is described here is actually a modified CCDA medium, a blood-free selective medium for isolation of Campylobacter spp. Cultivation on CCDA plates is performed at 37 or 42°C after surface spreading and incubation under a microaerophilic atmosphere in the presence of CO2 .
CCDA medium contains:
- nutrient broth (nitrogen, vitamin and mineralsource)
- casein hydrolysate (nitrogen, vitamin and mineralsource)
- bacteriological charcoal (absorbs toxic substances and metabolites)
- sodium deoxycholate (inhibits enteric bacteria, which are gram negative, except Campylobacter spp.)
- ferrous sulfate (iron(II) sulfate, which neutralizes toxic oxygen products)
- amphotericin (inhibits yeast and fungi)
- cefoperazone (inhibits enteric bacteria, which are gram negative, except Campylobacter spp.)
- sodium pyruvate (neutralizes toxic oxygen products)
- agar (gelifying agent)
- water
The final pH of the medium should be 7.4.
Other comments:
Campylobacter spp. colonies are flat and round to irregular with smooth edges. On CCDA agar the colonies are often translucent and greyish-white with a metallic sheen. Colonies of some strains may spread to a continous film (svarming) on moist agar.
Updated: 2019-10-09.
ContentsCefsulodin-Irgasan-Novobiocin (CIN) agar
Applications:
CIN (Cefsulodin-Irgasan-Novobiocin) agar is a differential and selective medium used in qualitative procedures for the isolation of Yersinia enterocolitica from different clinical and nonclinical samples. Escherichia coli, Klebsiella pneumoniae, Proteus mirabilis, Pseudomonas aeruginosa, Salmonella enterica, Shigella sonnei and Streptococcus faecalis do not grow on CIN agar. By reducing the concentration of cefsulodin, CIN Agar could also be used for selective isolation of Aeromonas spp.
The medium contains:
- mannitol
- peptone (carbon and nitrogen source)
- protease peptone (carbon and nitrogen source)
- yeast extract (B-vitamin etc.)
- sodium pyruvate (stimulates growth of Yersinia spp.)
- NaCl (maintains the osmotic balance of the medium)
- sodium deoxycholate (inhibits growth of gram positive and many gram negative bacteria)
- sodium cholate (inhibits growth of gram positive and many gram negative bacteria)
- neutral red (pH indicator)
- MgSO4 (stimulates growth of Yersinia
- Irgasan (inhibits gram positive and many gram negative bacteria)
- Cefsulodin (inhibits the normal flora of enteric bacteria)
- Novobiocin (inhibits the normal flora of enteric bacteria)
- crystal violet (inhibits growth of gram positive and many gram negative bacteria)
- agar (gelifying agent)
- H2O
The final pH of this medium should be 7.4.
Other comments:
Differentiation of bacteria is based on mannitol fermentation. Organisms which are capable of fermenting mannitol will decrease the pH around the colony and the corresponding colour change of neutral red will generate colonis that appear as red. Because of the localized pH decrease, a zone of precipitated bile may also be present. The appearance of the colonies has some similarity with a "bull's eys". Organisms that do not metabolize mannitol to acid will form colorless, translucent colonies.
Updated: 2018-05-09.
ContentsChrome agar
The figure shows Chrome agar plates with cefotaxime, where bacteria have not been cultivated on plate A. Escherichia coli (to the left) and Enterococcus spp. (to the right) have been cultivated on plate B. Faeces samples with a mixed culture of E. coli and Enterococcus spp. from a calf have been cultivated on plates C and D . Note the coulur differences, E. coli colonies have a pink colour and Enterococcus spp. are turquoise blue. Since cefotaxime has been added to these Chrome agar plates, the growth on these plates indicate that the bacteria are resistant to carbapenem (ESBL producing). The Images is photographed with lighting from below - Click on the image to enlarge it.
Image: Ingrid Hansson (SLU), Lise-Lotte Fernström (SLU) & Karl-Erik Johansson (SLU).
Applications:
Chromogenic media facilitate the isolation and differentation of bacteria as specific bacteria grow with different distinct colony appearance. There are different variants of chromogenic agar, which can be used for cultivation and sometimes also for differentitation of bacteria, for instance:
- bacteria which may cause urinary tract infections (see table below)
- thermotolerant Campylobacter spp.
- Salmonella serovars
- Clostridium perfringens
- Clostridioides difficile
- Group A streptococci
- Group B streptococci
- antibiotics resistant bacteria, e.g. ESBL producing (see figure), VRE and MRSA/MRSP (which require addition of the respective antibioticum)
Content of the medium:
- agar (gelifying agent)
- peptone
- yeast extract
- chromogenic mix (the composition varies with purpose and the manufacturer)
The final pH of this medium used to be 7.0.
Other comments:
Colonies of different bacteria will appear in different colours, bellow are some examples.
| Bacterial genus or species | Appearance of colonies |
|---|---|
| Citrobacter, Enterobacter, Klebsiella, Serratia | metallic blue (+/- reddish halo) |
| E. coli | dark pink to reddish |
| Enterococcus | turquoise blue |
| Morganella, Proteus, Providencia | brown halo |
| Pseudomonas | translucent (+/- natural pigmentation cream to green) |
| S. aureus | golden, small opaque |
Updated: 2019-10-24.
ContentsColistin-Oxolinic Acid-Blood Agar (COBA)
The figure shows a COBA plate, on which Streptococcus equi subsp. zooepidemicus, that produces β-hemolysis has been cultivated. The plate is shown with lighting from above (A) and from below (B). - Click on the image to enlarge it.
Applications
Colistin-Oxolinic Acid-Blood Agar (COBA) is a selective medium, which is used for isolation of streptococci. The medium contains antibiotics that inhibits growth of gramnegative bacteria
Content of the medium:
COBA is a blood agar based medium, which contains colistin sulfate and oxolonic acid.
Other comments:
Most streptococci are not inhibited by colistin sulfate and oxolonic acid, whereas members of the family Enterobacteriace, Pseudomonas aeruginosa, staphylococci and corynebacteria are inhibited.
Updated: 2019-05-28.
ContentsCysteine Lactose Electrolyte Deficient (CLED) agar
The figure shows CLED agar plates, where bacteria have not been cultivated on plate A. On plates B and C, Proteus vulgaris and Escherichia coli, respectively, have been cultivated. Note the colour change of plate C, where E. coli has been cultivated. Proteus spp does normally not swarm on CLED agar, but if the colonies are very close together and if the plate has been incubated for too long time, swarming may occur, which can bee seen within certain areas of plate B. Staphylococcus pseudintermedius has been cultivated on plate D. - Click on the image to enlarge it.
Image: Karl-Erik Johansson (BVF, SLU) and Lise-Lotte Fernström (BVF, SLU).
Applications:
Cysteine Lactose Electrolyte Deficient (CLED) agar is a non-inhibitory growth medium used for isolation and differentiation of bacteria that cause urinary tract infections. Since CLED agar is electrolyte (salt) deficient, it can be used to prevent the swarming of Proteus spp.
Content of the medium:
- enzyme digested gelatin (contains amino acids and peptides)
- enzyme digested kasein (contains amino acids and peptides)
- meatextract (contains vitamines and is a carbon and nitrogen source)
- lactose (carbon source)
- bromothymol blue (pH-indicator)
- L-cystine (growth factor for cystin dependent coliform bacteria)
- agar (solidifying substans)
- water
The final pH is approximately 7.3.
Other comments:
Lactose fermenters produce colonies that appear as yellow, whereas colonies of non-lactose fermenters appear blue on CLED agar.
E. coli forms colonies, which appear as yellowish, because the agar will turn yellowish.
Proteus spp. form colonies that appear as light bluish, because the agar stays blue.
Klebsiella spp. form extremely mucoid colonies. These colonies may vary in colour from appearing as yellowish to light bluish and the agar will turn yellowish.
Updated: 2019-09-05.
ContentsDip slide
In the first column (A, C and E) the figure shows the side of the dip slide (Uricult), which is covered by E. coli agar to the left and MacConkey agar to the right. The other side of the dip slide, which is covered by CLED agar, is shown in the second column (B, D and F) . Bacteria has not been applied in the first row (A and B). In the second row (C and D), Escherichia coli has been applied. In the third row (E and F), Proteus vulgaris has been applied. - Click on the image to enlarge it.
Image: Karl-Erik Johansson (BVF, SLU) and Lise-Lotte Fernström (BVF, SLU).
Introduction:
Dip slide is a test system for detection of microorganisms in liquids. The system consists of a tightly sealed plastic jar containing a slide with agar based culture media on one or two sides. The slide is immersed in the liquid to be analyzed. The liquid can also be flushed over the slide with a Pasteur pipette. The slide is then put back in its original container and incubated at the appropriate temperature for 1-2 days. Then the result is read. There are systems developed for different applications. In veterinary and human medicine dip slides are often used for analysis of urine samples.
Dip slides for urine samples:
There are several commercial systems developed for urine samples and in veterinary medicine, Uricult® Trio is often used in Sweden (see figure). In this system, one side of the slide is covered with CLED agar and half of the other side is covered with MacConkey agar and the other half is covered with E. coli-agar. Most pathogens of the urinary tract grow on CLED agar and if they are lactose fermenting, the colour of CLED agar changes from green to yellow. The MacConkey agar is used to grow mainly gram negative bacteria. On E. coli-agar, E. coli strains producing β-glucuronidase, will form grey-brownish to brown-blackish colonies. Other bacteria that grow leaves no color change in the colonies.
Updated: 2018-05-09.
ContentsEnrichment medium
See Growth media.
Updated: 2018-05-09.
ContentsFastidious anaerobic agar (FAA)
The figure shows an FAA-plate on which bacteria have not been cultivated. Note the colour, which is darker than ordinary blood agar plates. - Click on the image to enlarge it.
Image: Karl-Erik Johansson (BVF, SLU) och Lise-Lotte Fernström (BVF, SLU)
Applications:
Fastidious anaerobic agar (FAA plates) are used for cultivation of anaerobic bacteria of clinical significance under oxygen-free conditions.
The medium contains:
- peptone (enzymatic digests of animal tissue or milk, which is a source for nitrogen, carbohydrates, and vitamines)
- starch and bicarbonate, which neutralize toxic metabolites
- hemin and vitamin K, which constitute growth factors for many anaerobic bacteria
- cysteine, which decreases the redox potential of the medium
- pyruvate, which contributes to the neutralization of hydrogen peroxide
- horse blood (5%), which contains nutrients and also makes it possible to observe hemolysis
Other comments:
Note that facultatively anaerobic bacteria are also growing on these plates, but not as good as on ordinary blood agar plates.
Updated: 2018-05-09.
ContentsGrowth media (Culture media)
Introduction
To isolate, identify and characterize bacteria you often (but not always) need to multiply them by culture and for this purpose liquid or solid media (substrates) are used. Media can be defined or undefined. In a defined medium all components used are known, whereas an undefined (or semi-defined) medium may contain different types of commersial extracts from plant or animal tissue where it is not known exactly which nutrients are included. Furthermore the composition of these extracts may vary from batch to batch. A minimal medium contains only those ingredients that are absolutely essential for a particular bacterium to grow. A riched medium contains many substances (e.g., serum, amino acids and nucleotides, as well as vitamins), which allows the actual bacterium to grow faster and to higher density (form bigger colonies).
Extracts, which are used in growth media
- tryptose (a mixture of enzymatically (trypsine) digested proteins)
- tryptone (enzymatically (trypsine) digested casein)
- peptone (a mixture of enzymatically (pankreatin and papain) digested proteins)
Liquid media
Liquid media are sterile nutrient solutions that are tailored to the bacteria you want to grow. An enrichment medium is a fluid medium, which is specially adapted to a particular bacterial species or group of closely related bacterial species. Enrichment media is used in order to be sure that a certain bacteria will grow, even if it is present in a small amounts only, in the original sample. In some cultivation for example Salmonella analysis pre-enrichment is used to stimulate the growth of all bacteria in the sample. Pre-enrichment is a non-selective enrichment and in Salmonella analysis it is used before the selective enrichment. Selective media can be liquid, semisolid or solid and they contain substances (e.g. antibiotics or other bacterial inhibitors), which will prevent some bacteria to grow. Selective media are used to increase the chances to be able to cultivate a slow-growing bacteria, which otherwise would easily be competed out.
Solid substrates
To get a solid substrates you mix a gel-forming substance with a liquid medium and heat the mixture until the substance dissolves. Then the solution is cooled until it solidifies. Agar is the most common gel-forming substance, but agarose can also be used, which is purified from agar. In some special cultivations (e.g. of mycobacteria) egg yolk is used as gelling agent. Semisolid media are produced by using a smaller amount of gelifying agent.
Additives
In order to facilitate identification of bacteria, a pH indicator is often added to the growth medium to see if the bacterium is producing metabilites the change the pH of the medium. When adding a pH indicator to the solid medium and the bacterium in question produces a metabolite that changes the pH of the medium resulting in a colour change, it may seem as if colonies also change colour. However, it is usually only the medium that changes color, but colonies are often translucent or semi-transparent and therefore it may seem as if they change colour too.
There are other more specific additives, which are also used for identification and that lead to a chemical reaction in the bacterium or on the bacterial surface, where one can really say that the colony has changed colour. For instance tellurite in Baird-Parker agar and the X-glucoside in Brilliance Listeria agar medium.
Updated: 2020-01-20.
ContentsHematin agar (= Chocolate agar)
The figure shows a hematin agar plate on which bacteria have not been cultivated. Note the colour, which is more brownish than ordinary blood agar plates or FAA plates. - Click on the image to enlarge it.
Image: Karl-Erik Johansson (BVF, SLU) and Lise-Lotte Fernström (BVF, SLU).
Applications:
Hematin agar , which is also called chocolate blood agar or simply chocolate agar, is a non-selective enrichment medium. This medium is used for isolation of fastidious bacteria as for instance Haemophilus spp. and Taylorella equigenitalis.
The medium contains:
- 10% fresh sheep blood
- beef extract (contains nutrients)
- peptone
- NaCl
- agar (gelifying agent)
- H2O
The pH of the medium should be 6,8. Hematin agar has basically the same composition as blood agar, but hematin agar is heated in a boiling water bath for 1 h until the colour has changed from red to chocolate brown.
Other comments:
When the blood has been heated as above, are the red blood cells lysed and hemin (X-factor) and NAD (V-factor) have been released. These substances are essential nutrients for some bacteria. The name chocolate agar is referring to the color of the medium and not to its content. Hemolysis cannot be observed on hematin agar. By adding some substances, the medium can be more selective.
Updated: 2018-05-09.
ContentsMacConkey agar
The image shows three plates with MacConkey agar. No bacteria were cultivated on the plate in image A. Escherichia coli and Proteus vulgaris have been cultivated during incubation at 37°C on the plates in the images B and C. Note the colour of the colonies, the, precipitation zone on the plate in image B and that P. vulgaris does not swarm on the plate in image C, which does not contain NaCl. - Click on the image to enlarge it.
Image: Karl-Erik Johansson (BVF, SLU) and Lise-Lotte Fernström (BVF, SLU)
Applications:
MacConkey agar is a selective culture medium, which is used to grow gram negative bacteria and to identify those which ferment lactose. It has proved useful for identification of intestinal bacteria. Purple agar (with lactose) is used in some laboratories instead of MacConkey agar
The medium contains:
- peptone (enzymatic digest of animal tissues or milk, which constitute a source of nutrients)
- lactose (to differentiate between lactose fermenters and non-fermenters)
- bile salts (inhibits gram positive bacteria)
- crystal violet (inhibits gram positve bacteria)
- NaCl (provides the osmotic balance)
- neutral red (pH indicator)
- agar (solidifying agent)
- H2O
The final pH of the medium should be 7.1. Many variants of MacConkey agar exist and e.g. NaCl can be omitted if you don't want Proteus spp. to swarm. Bile salts and crystal violet inhibit most gram positive bacteria. Neutral red is colorless at any pH greater than 6.8 and turns red at a pH below 6.8.
Other comments:
- Lactose fermenting bacteria (Escherichia coli, Enterobacter spp. and Klebsiella spp.) form colonies that seem to be red or pink, because acid is formed and the medium change colour when lactose is fermented.
- Non-lactose fermenting bacteria (Proteus spp, Pseudomonas aeruginosa, Salmonella spp and Shigella spp.) form yellowish, white or colourless and translucent colonies.
- Some gram negative bacteria such as the bacteria belonging to Family Pasteurellaceae do not grow on MacConkey agar.
Updated: 2021-10-10.
ContentsMannitol egg Yolk Polymyxin agar (MYP agar)
The figure shows MYP agar plates. Plate A is a contol and lacks bacteria. On plate B, suspected colonies of Bacillus cereus have been cultivated. A precipitation can be seen around the streak of bacteria, because lecithin is split into an insoluble diglyceride. For comparison, both Staphylococcus aureus subsp. aureus (to the left) and B. cereus (to the right) have been cultivated on plate C. There is no precipitation around the streak of S. aureus subsp. aureus and, furthermore, manitol is fermented by S. aureus subsp. aureus. - Click on the image to enlarge it.
Image: Ingrid Hansson (SLU), Lise-Lotte Fernström (SLU) & Karl-Erik Johansson (SLU).
Applications:
Mannitol egg Yolk Polymyxin agar (MYP Agar) is a selective medium for detection and enumeration of Bacillus cereus in food samples. MYP Agar is also called MCS (Mossel Cereus Selective) agar or BCS (Bacillus Cereus Selective) Agar. MYP agar contains mannitol, which B. cereus does not ferment and egg yolk, which in turn contains lecithin that can be cleaved by the phospholipase C of B. cereus. Additionally MYP agar contains polymyxin, which inhibits gram negative bacteria.
MYP agar contains:
The final pH of the medium should be 7.2. Egg yolk and polymyxin are aseptically added when the medium has been sterilized.
- Meat extract
- Pepton
- Mannitol
- NaCl
- Phenol red
- Agar
- Water
Other comments:
If B. cereus is growing on MYP agar a precipitate is formed around the colonies or the streak, and you will not get any yellowing because B. cereus does not ferment mannitol and there will be no decrease in pH around the colonies or the streak.
Updated: 2023-05-03.
ContentsModified Semisolid Rappaport Vassiliadis (MSRV) agar
The figure shows four MSRV agar plates. Bacteria have not been cultivated on the plate in image A. On the plate in image B has a bacterium, which is not a Salmonella sp. been applied. Salmonella enterica subsp. enterica has been applied onto the plates in images C and D. The plates in the images B and D have been incubated during 48 h at 41,5°C and the plate in image C has been incubated during 24 h at the same temperature. Note that the blue colour on plate C has completely disappeared after 48 h (plate D), because Salmonella spp. has been swarming over the surface of the agar and forms a grey continuous layer.
Image: Karl-Erik Johansson, Ingrid Hansson and Lise-Lotte Fernström (BVF, SLU). - Click on the image to enlarge it.
The figure shows four MSRV agar plates. Bacteria have not been cultivated on the plate in image A. On the plate in image B has a bacterium, which is not a Salmonella sp. been applied to the right of the arrows, where you can see grey zones of bacteria. Salmonella enterica subsp. enterica has been applied onto the plates in images C and D. The plates in the images B and D have been incubated during 48 h at 41,5°C and the plate in image C has been incubated during 24 h at the same temperature. Note that the blue colour still can be discerned on plate C after 24 h, but has completely disappeared on plate D after 48 h, because Salmonella spp. has been swarming over the surface of the agar and forms a grey continuous layer.
Image: Karl-Erik Johansson (BVF, SLU) and Lise-Lotte Fernström (BVF, SLU).
Applications:
Modified Semisolid Rappaport Vassiliadis (MSRV) agar is a selective enrichment medium for rapid detection of motile Salmonella spp. in feces and food products. When the MSRV agar plate is used, 100 µl of sample is distributed on three sites (see figure).
Content of the medium:
The difference between RVS medium and MSRV medium is that the MSRV medium contains a low koncentration of agar, which makes it possible for motile strains of Salmonella spp. to swarm in contrast to most other motile strains of bacteria. Most Salmonella strains are motile. Furthermore, the MRSV-medium also contains Novobiocin, which increases the selectivity.
Other comments:
No heavy greyish swarming zone is visible in a salmonella negative sample, whereas salmonella positive samples give a very heavy swarming, which covers the complete plate within 24-48 h.
Updated: 2020-08-18.
ContentsPlate count agar (PCA)
The figure shows four PCA plates. Bacteria have not been cultivated on the plate in image A. On the plate in image B, 4 colonies could be calculated, on plate C 45 colonies and plate D >250 colonies. The plates in the images B, C and D originated from the same sample and have been been diluted by a tenfold dilution serie and the pour-plated by PCA. The plates have been incubated during 72 h at 30°C.
- Click on the image to enlarge it.
Image: Ingrid Hansson, Lise-Lotte Fernström och Karl-Erik Johansson (BVF,SLU)
Applications
Plate count agar (PCA) or Standard PCA is a bacteriological substrate used for determination of the total number of live, aerobic bacteria in a sample. Thus, PCA is not a selective medium. The amount of bacteria is expressed as colony forming units per gram (CFU/g), in solid samples and per ml (CFU/ml) in liquid samples. This value can be determined by making a tenfold dilution series of the sample. Then, 1 ml is taken from each dilution and applied on a petri dish and an overlay of 10-15 ml PCA is added by using the pour-plate technique, the plates are incubated at 20 or 30°C in three days. After incubation the number of colonies is counted on the plate with 25-250 colonies, which is considered to give the most accurate result. When calculating the actual number of bacteria in the sample, the dilution factor has to be considered.
The medium contains:
- tryptone (contains amino acids)
- yeast extract (contains peptides, sugars, minerals and B vitamins)
- glucose (carbon source)
- agar (gelifying agent)
- water
The final pH of the medium should be 7.0
Other comments:
The medium is straw-coloured (pale tan) and if colonies are present, they therefore also appear as straw-coloured.
Updated: 2018-05-09.
ContentsPurple agar
The figure shows plates with purple agar and no bacteria have been cultivated on plate A. A lactose fermenter (Escherichia coli) and a non-lactose fermenter (Salmonella enterica subsp. enterica) have been cultivated on plates B and C, respectively. Note the colour change because of a pH drop in plate B. - Click on the image to enlarge it.
Image: Karl-Erik Johansson (BVF, SLU) and Lise-Lotte Fernström (BVF, SLU).
Applications:
Purple agar with lactose is often used for the detection and typing of members of the family Enterobacteriaceae, beacuse it can be used for discrimination of lactose fermenters and non-lactose fermenters. MacConkey agar is used in some laboratories instead of purple agar (with lactose).
The medium contains:
- peptone (enzymatic digest of animal tissues or milk, which constitute a source of nutrients)
- beef extract ( source of nutrients)
- lactose (to differentiate between lactose fermenters and non-fermenters)
- NaCl (provides the osmotic balance)
- sodium ammonium phosphate (buffering agent)
- bromcresol purple (pH indicator)
- agar (solidifying agent)
- H2O
The pH of the medium should be 6.8 and at this pH bromcresol purple is bluish-purple. Lactose fermenting bacteria lower the pH of the medium to acid, which causes the medium to change in colour from blue-purple to yellow. Lactose can be replaced with for instance maltose or trehalose to determine if a certain bacterium is able to ferment these carbohydrates. These modified media are used for other bacteria than members of the family Enterobacteriaceae, for instance members of the genus Staphylococcus.
Other comments:
- Bacteria, which ferment the contained carbohydrate, form colonies, which appear to be yellowish, because the surrounding agar turns yellow.
- Bacteria, which do not ferment the contained carbohydrate, form colonies, which apper to be light purple, because the surrounding agar remains purple.
Updated: 2018-05-09.
ContentsRappaport-Vassiliadis Salmonella (RVS) enrichment medium

RVS broth contans: Soya peptone MgCl2, NaCl phosphate malachite green The final pH should be 5.2.
The selectivity of the medium is due to the presence of malachite green, high osmotic pressure, and a low pH. The high concentration of magnesium chloride raises osmotic pressure, and in combination with malachite green, inhibits bacteria other than Salmonella spp. The low pH of the medium increases selectivity by inhibiting accompanying flora, including intestinal bacteria.
Updated: 2012-12-04.
ContentsSelective medium
See Growth media.Updated: 2013-02-06.
ContentsSELMA plate
The figure shows two different SELMA plates under two different light conditions. Bacteria has not been cultivated on plates A and B, but on plates C and D, Staphylococcus aureus subsp. aureus has been cultivated. Plates A and C were photographed with a dark background and with lighting from above. Plates B and D were photographed with lighting from below. - Click on the image to enlarge it. - Click on the image to enlarge it.
Image: Karl-Erik Johansson (SLU), Ingrid Hansson (BVF) and Lise-Lotte Fernström (BVF, SLU).
Applications:
SELMA plates are used for identification of bacteria, which may cause mastitis, and should only be used for milk samples. SELMA means SELective MAstitis medium and there are two variants of SELMA plates. SELMA, which has three sectors and SELMA PLUS, which has four sectors with different growth media. On this page, only SELMA plates are shown and the sectors are numbered on the back of the plate.
The sectors contain:
- Bovine blood agar with esculine where most aerobic (and facultatively anaerobic) bacteria grow.
- MacConkey agar where only gram negative bacteria grow.
- Mannitol salt agar where staphylococci and enterococci grow. Gram negative bacteria are inhibited by the high salt concentration. Mannitol salt agar can also be used to determine the production of penicillinase in staphylococci (se link below).
Other comments:
Note the double hemolysis of Staphylococcus aureus subsp. aureus can be observed on bovine blood agar with lighting from below. Decreased pH can be observed in the mannitol salt agar, where S. aureus subsp. aureus has been cultivated, but this bacterium does not grow on MacConkey agar.For more information, see the SVA website, and "Användarinstruktion: Selma & Selma Plus", where the plates are observed from above.
Updated: 2018-05-09.
ContentsSELMA PLUS plate
The figure shows two different SELMA PLUS plates under two different light conditions. Bacteria has not been cultivated on plates A and B, but on plates C and D, Escherichia coli has been cultivated. Plates A and C were photographed with a dark background and with lighting from above. Plates B and D were photographed with lighting from below. - Click on the image to enlarge it. - Click on the image to enlarge it.
Image: Karl-Erik Johansson (SLU), Ingrid Hansson (BVF) and Lise-Lotte Fernström (BVF, SLU).
Applications:
SELMA plates are used for identification of bacteria, which may cause mastitis, and should only be used for milk samples. SELMA means SELective MAstitis medium and there are two variants of SELMA plates. SELMA, which has three sectors and SELMA PLUS, which has four sectors with different growth media. On this page, only SELMA PLUS plates are shown and the sectors are numbered on the back of the plate.
The sectors contain:
- Bovine blood agar with esculine where most aerobic (and facultatively anaerobic) bacteria grow.
- MacConkey agar where only gram negative bacteria grow.
- PGUA-agar (β-glucoronidas-agar), which is used for direct identification of Escherichia coli.
- Mannitol salt agar where staphylococci and enterococci grow. Gram negative bacteria are inhibited by the high salt concentration. Mannitol salt agar can also be used to determine the production of penicillinase in staphylococci (se link below).
Other comments:
Note that E. coli is growing on all media except mannitol salt agar. Note also the colour change from blue to green in the PGUA-agarn because E. coli has a β-glucoronidase and the colour change around the colonies in the MacConkey agar because of the decreased pH.
For more information, see the SVA website, and "Användarinsruktion: Sema & Selma Plus", where the plates are observed from above.
Updated: 2018-05-09.
ContentsSlanetz and Bartley agar
The figure shows plates with SlaBa agar. Bacteria ave not been cultivate on plate A and Enterococcus faecalis has been cultivated on plate B. Note the colour of the colonies. - Click on the image to enlarge it.
Image: Karl-Erik Johansson (BVF, SLU) and Lise-Lotte Fernström (BVF, SLU).
Applications
Slanetz and Bartley agar (SlaBa agar) is a selective medium, which is used for surface streaking and enumeration of Enterococcus spp. in drinking water, beverages and other biological products of animal origin. Cultivation on SlaBa agar is performed at 44°C after surface spreading.
SlaBa agar contains:
- tryptose (contains peptides)
- yeast extract (contains peptides, sugars, minerals and B vitamins)
- glucose (carbon source)
- KH(PO)4
- sodium azide [(NaN3) inhibits growth of Gram-negative bacteria]
- triphenyltetrazolium chloride [(TTC) is an indicator of bacterial growth]
- agar (gelifying agent)
- water
The final pH of the medium should be 7.2.
Other comments
When bacteria grow, TTC is reduced to a product which is called formazan and this will change the colour of the colonies to red to maroon.
Updated: 2018-05-09.
ContentsSmith-Baskerville medium
The figure shows agar plates with Smith-Baskervill medium, where bacteria have not been cultivated on plate A. Bordetella bronchiseptica has been cultivated on plates B. Note the colour change from green to blue in the plate whith Bordetella bronchiseptica, which is due to the fact that this bacterium is aerobic and does not ferment carbohydrates. Thus, the medium will turn alkaline during growth. On the upper part of the plate, there is not a sufficient amount of bacterial colonies for colour change of the medium. - Click on the image to enlarge it.
Image: Karl-Erik Johansson (BVF, SLU) and Lise-Lotte Fernström (BVF, SLU)
Applications
Smith-Baskerville (S-B) medium is a selective medium for cultivation of Bordetella bronchiseptica.
The medium contains:
- glucose
- lactose
- gentamycin
- furaltadon
- penicillin
- bromothymol blue (pH indicator)
- agar (solidfying agent)
- H2O
The final pH of the medium should be 6.8 at which bromothymol blue is green. The medium turns blue at alkaline pH.
Other comments:
- Colonies of B. bronchiseptica and B. avium are 1-2 mm in diameter after incubation for 48 h at 37°C. The colour of the colonies and the surrounding medium is blue.
- Non-fermenting contaminants (Alcaligenes spp., Pseudomonas spp. and Flavobacterium spp.) are larger and more greenish than Bordetella spp.
- Fermenting contaminants will produce acid with resulting yellow colonies and surrounding medium.
Updated: 2018-05-09.
ContentsTryptic soy agar (TSA) + VRG
The image shows a combined TSA and VRG agar plate. On plate A, no bacteria have been streaked out, while Escherichia coli has been streaked out on plate B. - Click on the image to enlarge it.
Applications:
"Tryptic soy agar (TSA)" is a general medium, which is used for isolation and enumeration of many different bacteria, among others, E. coli.
The medium contains:
- casein peptone (contains amino acids and peptides)
- soya peptone (contains amino acids and peptides)
- NaCl (contributes to the osmotic balance)
- agar (gelifying agent)
- water
The final pH of the medium should be 7.3.
Other comments:
TSA is often used in combination with VRG agar. TSA is then mixed with the sample to be analyzed at around 40°C and poured into the plates. After preincubation for 1-2 h at ambient temperature, the TSA is overlayed with VRB agar and the incubation is then continued at 37°C.
Updated: 2026-03-20.
ContentsTryptose Sulfite Cycloserine agar
The figure shows three TSC agar plates, where no bacteria have been cultivated on plate A. Clostridium perfringens has been cultivated on plates B and C. Plate C contains lecithin, but not plate B. Note the precipitation zone of diglycerides around the colonies on plate C.- Click on the image to enlarge it.
Image: Ingrid Hansson (SLU), Lise-Lotte Fernström (SLU) & Karl-Erik Johansson (SLU).
Applications:
Tryptose Sulfite Cycloserine agar (TSC agar) is used for isolation and enumeration of both vegetative cells and spores of Clostridium perfringens in food and clinical samples.
The medium contains:
- meat peptone (contains amino acids and peptides)
- soya peptone (contains amino acids and peptides)
- yeast extract
- ammonium ferric citrate (see below)
- sodium disulfite [is reduced to sodium sulfide (by some bacteria), which forms a black precipitate (FeS) with ammonium ferric citrate]
- lecithin (optional)
- cycloserin (inhibits the background flora of bacteria)
- agar (gelifying agent)
- water
The final pH of the medium should be 7.6.
Other comments:
Hydrogen sulfide (H2S) positive bacteria (as e.g. C. perfringens) form black colonies on TSC agar. If the TSC agar contains lecithin, a precipitation zone will be formed around colonies, which produce lecithinase.
Updated: 2019-06-11.
ContentsViolet red bile agar (VRB agar)
The figure shows a VRG agar plate on which coliform bacteria have been cultivated. - Click on the image to enlarge it.
Image: Ingrid Hansson (SLU), Lise-Lotte Fernström (SLU) & Karl-Erik Johansson (SLU).
Applications:
Violet red bile agar (VRB agar) is a selective medium, which is used for enumeration of coliform bacteria in water, milk and other dairy produts.
The medium contains:
- peptone (contains amino acids and peptides)
- yeast extract (contains peptides, sugars, minerals and B vitamins)
- NaCl (contributes to the osmotic balance)
- bile salts (inhibit gram positive bakteria)
- lactose (carbon source)
- neutral red (pH-indicator)
- crystal violet (inhibit gram positive bakteria)
- agar (gelifying agent)
- water
The final pH of the medium should be 7.4.
Other comments:
VRB agar is often used in combination with TSA (Tryptone Soya Agar) for the detection and enumeration of thermotolerant coliform bacteria (including E. coli). A thin layer of TSA (containing the sample with bacteria) is then molded in the bottom of the plate, which is then incubated for 1-2 h. at ambient temperature. Another layer consisting of VRG-agar is then molded on top on the TSA and the plate is incubated further.
Updated: 2023-05-31.
ContentsViolet Red Bile Glucose (VRBG) agar
The figure shows three VRBG agar plates. Bacteria have not been cultivated on the plate in image A. Two different members of the family Enterobacteriaceae have been cultivated at 37°C during 24 h on the plates B and C. A halo can be discerned around the colonies because of precipitated bile salts, which also makes the colonies look unsharp. This is particularly evident on the plate in image C.
Image: Karl-Erik Johansson (BVF, SLU) and Lise-Lotte Fernström (BVF, SLU).
Applications:
Violet Red Bile Glucose (VRBG) agar is a selective medium, which is used for isolation and enumeration of members of the family Enterobacteriaceae in food products.
Content of the medium:
- peptone (contains amino acids and peptides)
- yeast extrakt (contains peptides, sugars, minerals and B vitamins)
- NaCl (contributes to the osmotic balance)
- bile salts (inhibit gram positive bacteria, except Enterococcus faecalis)
- glucose (carbon source)
- neutral red (pH-indicator)
- crystal violet (inhibit gram positive bakteria)
- agar (gelifying agent)
- water
The final pH of the medium should be 7.4.
Other comments:
Members of the family Enterobacteriaceae produce small (1-2 mm in diameter), round and violet to pink colonies with a halo on VRBG agar. There are some other genera, which also grow on VRBG agar, e.g. Aeromonas. The identity of the colonies must, therefore, be confirmed by an independent method, e.g. the oxidase test.
Updated: 2023-05-31.
ContentsXylose lysine deoxycholate agar (XLD agar)
The figure shows three XLD agar plates. Bacteria were not cultivated on the plate in image A. On the plate in image B, Salmonella sp. has been cultivated. Note that the colonies are pink with a black centre. On plate C, E. coli has been cultivated. Note the colour change of the upper part of the plate, where E. coli (lactose fermenter) colonies appear.- Click on the image to enlarge it.
Image: Karl-Erik Johansson (BVF, SLU) and Lise-Lotte Fernström (BVF, SLU).
Applications:
Xylose lysine deoxycholate agar (XLD agar) is a selective growth medium, which is used for isolation of Salmonella spp. and Shigella spp. from clinical samples and from food. The pH of XLD agar is 7.4 and it contains the pH indicator methyl red, which gives a red or pink colour.
Content of the medium:
- yeast extract
- sodium chloride (NaCl)
- xylose
- lactose
- sucrose
- lysine
- sodium thiosulfate
- iron ammonium citrate
- phenol red
- sodium deoxycholate
- agar
- water
Many enteric bacteria (except Shigella spp.) ferment xylose under acid production. Therefore, these bacteria form yellow colonies on XLD agar, but Salmonella spp. can decarboxylate lysin, which increases the pH and the colonies remain red. Furthermore, Salmonella spp. produce hydrogen sulfide (H2S) from thiosulfate, which results in a black precipitate with ferric salts.
Other comments:
- Salmonella colonies: red to pink (since the background is red) with black centre.
- Shigella colonies: red (since the background is red).
- Colonies of coliform bacteria: yellow or orange (since the background has this colour).
- Colonies of Pseudomonas aeruginosa: pink (since the background is red), flat and rough.
Updated: 2019-09-25.
Contents

![Click to enlarge (opens in a new window). Violet red bile agar (VRB agar) [under revision]](/images/terms/DSC_1862_yyy_L1000.jpg)